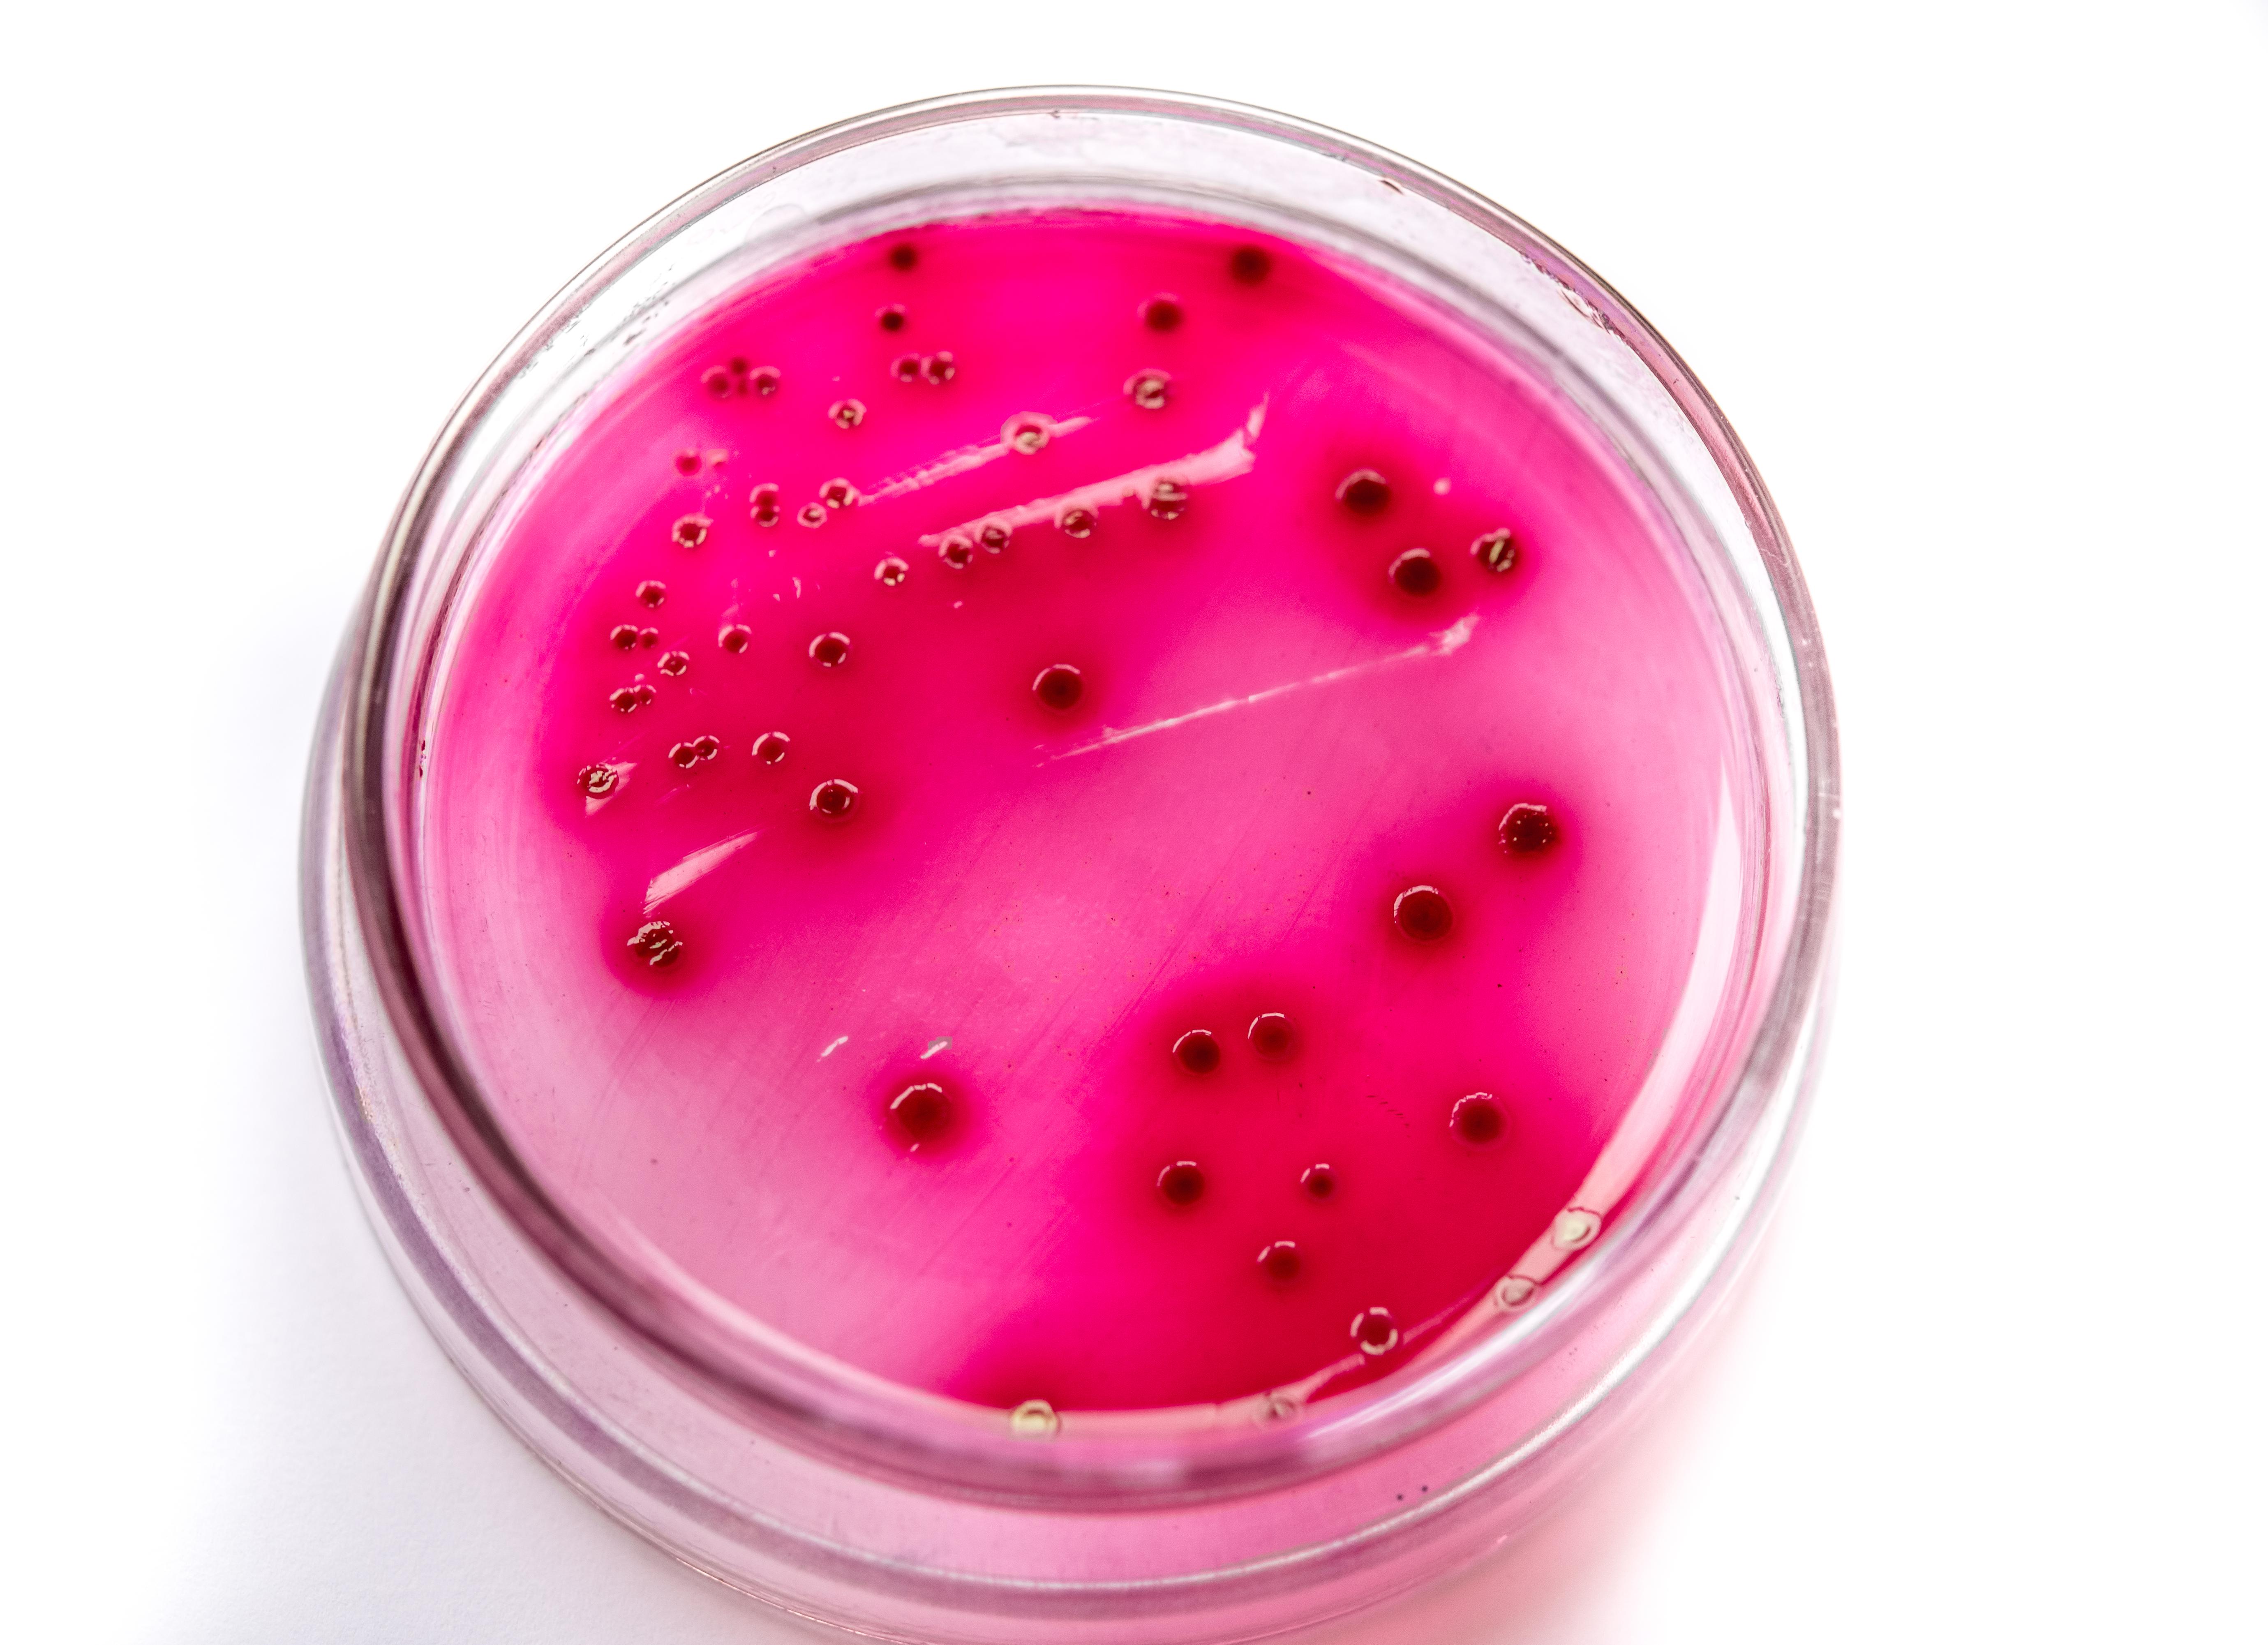
Что такое кишечная палочка

[Что такое кишечная палочка]
[Что такое кишечная палочка]
Кишечная палочка: симптомы и лечение — Полон жизни
Кишечная палочка на латыни называется Escherichia coli (E. coli) и представляет собой вид бактерий, включающий в себя патогенные и непатогенные разновидности. Патогенные разновидности кишечной палочки вызывают инфекционно-воспалительные заболевания органов пищеварительного тракта, мочевыделительной и половой системы у мужчин и женщин.
Дальше, мы детально рассмотрим, какие бывают виды кишечных палочек, причины их попадания в организм человека, первые симптомы и методы лечения у взрослых.
Что такое кишечная палочка?
Кишечная палочка (Escherichia coli) — бактерии, относящиеся к роду Escherichia и семейству Enterobacteriaceae. Эти микроорганизмы обладают высокой устойчивостью, они способны жить месяцами в воде, почве, фекалиях.
Группа заболеваний, связанных с кишечной палочкой и вызываемые патогенными штаммами бактерии, называется эшерихиозы. Выступают как причины возникновения заболевания кишечника, почек и других органов. Это создаёт ряд проблем в области пищеварения, мочеполовой системы.
Бактерии быстро и хорошо размножаются в продуктах питания, особенно в молоке, а потому съедание зараженных и обсемененных кишечной палочкой блюд вызывает заражение с последующим развитием инфекционно-воспалительного заболевания.
Классификация
Кишечные палочки бывают условно-патогенные (к которым относится гемолизирующая кишечная палочка) и патогенные. Учёные смогли выделить больше сотни патогенных штаммов этой бактерии, которые впоследствии были разделены на четыре основных класса, а именно:
- энтероинвазивные;
- энтеротоксигенные;
- энтеропатогенные;
- энтерогеморрагические.
Эти микроорганизмы могут стать причиной развития эшерихиозов – заболеваний инфекционного характера, которые по статистике чаще всего встречаются у детей и женщин (инфекция передаётся фекально-оральным путём в основном через пищу или воду).
| Форма | Особенности Escherichia coli |
| Энтеропатогенный эшерихиоз | Острая кишечная инфекция, вызванная энтеропатогенной палочкой. Часто заболевание поражает новорожденных детей, малышей от рождения до года.Частое клиническое проявление:
Малыш начинает часто срыгивать, отказывается от пищи. Сон ребёнка нарушается, он становится беспокойным. Болезнь протекает в затяжной форме не интенсивно. |
| Энтеротоксигенные | Такая разновидность поражения кишечной палочкой напоминает картину пищевого отравления. Отличительные характеристики:
Заболеванию подвержены взрослые, дети всех возрастов. Часто встречается у путешественников. |
| Энтероинвазивная | Энтероинвазивная кишечная палочка вызывает острые пищевые токсикоинфекции у детей и взрослых, течение которых похоже на дизентерию. |
| Энтерогеморрагическая | Энтерогеморрагическая (гемолитическая, гемолизирующая) кишечная палочка вызывает геморрагический колит у детей и взрослых или гемолитико-уремический синдром (ГУС). Оба заболевания требуют лечения. |
Причины попадания в организм
Кишечная палочка существует и размножается при условии температуры окружающей среды на уровне 37 градусов. Она питается в кишечнике минеральными веществами и продуктами распада аминокислот. Сохраняет свою жизнеспособность, попадая в водоемы, почву и продукты.
Род эшерихий относится к семейству энтеробактерий. Наибольшая группа разновидностей микроорганизмов полезна для организма. Часть штаммов носит патогенный характер – появляется ряд тяжёлых пищевых отравлений, мочеполовых инфекций. При тяжёлых иммунодефицитных состояниях, когда кишечная палочка распространилась по организму, способна привести к развитию менингита, сепсиса.
Главной причиной заражения кишечными инфекциями является несоблюдение гигиенических норм.
Выделяют 2 пути, по которым передается инфекция:
- Водный. Инфекция проникает в организм через употребление некипяченой воды или некачественной.
- Алиментарный. Он характеризуется приемом зараженной пищи. При таком способе заражения нередко встречаются пищевые отравления у человека, который использовал для приготовления пищи обсемененную продукцию. Для организма человека такая пища является ядом.
Оральным путем эшерихия коли попадает в кишечный тракт из:
- грязи на руках;
- грязи на овощах и фруктах;
- недостаточно обработанного термически мяса;
- зараженной сырой воды;
- сырого молока (согласно статистике, этот способ передачи является наиболее распространенным).
Контактно-бытовой путь передачи встречается редко. Чаще его можно наблюдать при вспышке эшехириоза в отдельном помещении (роддоме, больнице, школе и т.д.). Одним из наиболее опасных путей заражения кишечной палочкой является передача инфекции во время родов от матери ребенку.
Симптомы кишечной палочки
Симптомы заражения кишечной палочкой проявляются по-разному, поэтому каждый класс патогенных бактерий необходимо рассматривать в отдельности. Состояние здоровья заражённого человека будет зависеть от того, в какую группу относятся и с какой скоростью размножаются кишечные палочки, симптомы заболеваний описаны ниже.
К общим признакам развития в организме патогенных кишечных палочек относятся такие симптомы, как:
- Нарушение пищеварительного процесса;
- Боли в зоне живота;
- Рвота и тошнота;
- Проявления метеоризма;
- Неприятный запах, ощущаемый изо рта;
- Слабость;
- Сонливость;
- Потеря аппетита;
- Повышенная температура тела;
- Падение артериального давления.
В зависимости от вида бактерий человек замечает у себя присутствие тех или иных признаков.
Симптомы в зависимости от вида бактерии
Эшерихиоз, вызванный энтероинвазивными палочками, вызывает поражение толстого отдела кишечника. Развивается заболевания с возникновения общеинтоксикационных симптомов:
- слабости,
- головной боли,
- озноба,
- повышения температуры.
Спустя несколько часов возникают схваткообразные боли внизу живота.
- Возникает диарея, стул сначала водянистый и обильный. Но по мере поражения толстой кишки развивается колит.
- Симптомами этого состояния являются частый жидкий или кашицеобразный стул с примесью слизи, прожилками крови.
Этот вариант эшерихиоза характеризуется доброкачественным течением. Температура и стул нормализуются уже спустя один-три дня.
Кишечные инфекции, вызванные энтеропатогенными кишечными палочками, у взрослых и детей старше 3 лет протекают по типу сальмонеллеза. То есть заболевание начинается остро:
- появляется тошнота,
- рвота,
- боли в животе,
- умеренно или незначительно повышается температура тела.
Стул становится жидким, водянистым и обильным, причем больной ходит в туалет по 2 – 6 раз в сутки. При дефекации испражнения буквально брызжут. Инфекция в среднем продолжается в течение 3 – 6 дней, после чего наступает выздоровление.
Энтеротоксигенные кишечные палочки опасны тем, что могут прикрепляться именно к слизистой оболочке кишечника, чем существенно нарушают его работу. Инфекция передаётся через немытые руки или фрукты, поэтому симптомы жизнедеятельности кишечных бактерий в человеческом организме иногда называют «диареей путешественника», которая сопровождается:
- водянистым поносом без крови,
- тошнотой,
- приступообразной болью в животе.
Проявления заражением энтерогеморрагической инфекции:
- Некроз;
- Присутствие кровяных сгустков (в кале);
- Перитонит;
- Диарея (водянистый стул).
Симптомы инфекции у ребенка отличаются более тяжелым течением, особенно при поражении новорожденных или детей, имеющих низкую массу тела.
Escherichia coli может вызывать заболевания и в других органах, помимо кишечника. В мочевыводящих путях эта бактерия способна также вызвать воспаление. У девушек и женщин этот риск является более высоким, чем у мужчин, т.к. у них имеется короткий путь из кишечника в уретру.
Осложнения
Некоторые разновидности палочек могут вызывать:
- отравления;
- колибактериоз;
- кишечный дисбактериоз;
- кольпит;
- простатит;
- воспаление мочеполовой системы, цистит;
- менингит у новорожденных.
В редких случаях воспалительные заболевания могут вызывать осложнения:
- перитонит;
- пневмонию;
- сепсис;
- мастит.
Опасно попадание любых бактерий во влагалище женщины. Это приводит к воспалению половых органов. Вначале появляется вульвовагинит или кольпит. Если вовремя не устранить возбудителя, инфекция поднимается к маточным трубам и матке. Развивается эндометрит. При дальнейшем движении бактерий вверх по организму они попадают в брюшную полость, наблюдается перитонит.
Болезнь, вызванная кишечной палочкой, проявляется по-разному и может иметь массу осложнений на органы и системы тела. Поэтому возбудителя необходимо выявить как можно раньше и незамедлительно приступить к лечению.
Диагностика
Инфекцию диагностируют на основе бактериологического исследования. Часто при наличии палочки в исследовательском материале, являющемся основной частью нормальной микрофлоры кишечника, очень сложно выделить чистую культуру патогенной бактерии. Если в организме протекает воспалительный процесс, рекомендуется срочное лечение. Для получения результата анализа используют:
- каловые и рвотные массы;
- кровь;
- мочу;
- гной;
- мазки или соскобы, взятые из слизистых половых органов.
Лечение кишечной палочки
Лечение кишечных инфекций, вызванных палочкой, обычно комплексное и включает в себя следующие пункты:
- Антибиотики. Антибактериальная терапия составляет основу лечения кишечной палочки. Тот или иной препарат назначается после определения чувствительности к нему микроорганизмов. Чаще всего рекомендуют антибиотики группы цефалоспоринов: Цефелим, Цефалексин, Левофлоксацин. Препараты принимаются курсами по 5-10 дней.
- Бактериофаги. Это препараты, уничтожающие бактерии более мягко и безопасно, чем антибиотики, но они бывают эффективны не всегда. К бактериофагам относят Секстафаг, Интести-бактериофаг и т.д.
- Обезболивающие препараты. Если боли в животе сильные, назначаются обезболивающие препараты типа Но-шпа, Брал, Спазмалин, Нурофен. Однако их нельзя принимать длительное время.
- Пробиотики (Линекс, Бифидумбактерин и т.д.) помогают восстановить нормальный баланс патогенных и полезных микроорганизмов в кишечнике.
Лечение эшерихиоза должно проводиться в стационаре:
- Легкие формы инфекции не требуют назначения антибактериальных средств.
- При среднетяжелых формах коли-инфекции назначают антибиотики из группы фторхинолонов (норфлоксацин, офлоксацин).
- При тяжелой форме эшерихиоза приписывают препараты из группы цефалоспоринов (цефотаксима), фторхинолонов совместно с аминогликозидами.
Кроме приема антибиотиков больному необходимо выполнять определенные правила лечения. Если у пациента наблюдается понос или рвота, то ему необходимо в обязательном порядке пить регидрационные растворы. С их помощью осуществляется восполнение потерянной жидкости и соли.
При каждом опорожнении кишечника и рвоте необходимо выпивать от 300 до 600 миллилитров регидрационного раствора. Для его приготовления может использоваться аптечный порошок в виде Трисоля, Регидрона, Глюкосолана.
Для обеспечения максимально качественного лечения инфекционных болезней, которые возникают при появлении кишечной палочки, рекомендуется прием энтеросорбентов:
- Полисорба;
- Энтеросгеля;
- Полифепана;
- Смекта;
- Фильтрума .
Соблюдение диетического рациона. Вылечить кишечную палочку можно при соблюдении особого режима питания. В меню должно входить больше каш, приготовленных на воде, слизистых супов, отварных овощей, нежирного мяса и рыбы, приготовленных на пару.
Категорически запрещено питаться копченостями, жирными и жареными блюдами, консервами, молоком, свежими фруктами, пряностями.
Профилактика
Кишечная палочка уничтожается при приготовления пищи, выпечке, пастеризации. Однако, это правило применимо при условии, что температура составляет, по меньшей мере, 70°С, и процесс продолжается, минимум, 2 минуты. В отличие от других, бактерия E.coli характерна устойчивостью к холоду, кислой среде, сушке и высокой концентрации соли.
Профилактические действия для предотвращения заболеваний, вызванных кишечными палочками:
- Соблюдение личной гигиены: тщательное мытье рук и лица после улицы и многолюдных мест, грамотный подход к интимной гигиене.
- Контроль чистоты употребляемых сырых продуктов и доведение до нужного состояния молока и мяса.
- Питье только качественной воды.
- Использование одежды одноразового использования в больничных учреждениях.
- Контроль гигиены и состояния здоровья домашних питомцев.
- Регулярная уборка жилых помещений с использованием надежных, но не агрессивных моющих средств.
- Осторожность к приемам пищи в заведениях общественного питания и во время отпуска в жарких странах.
Источник: https://simptomy-i-lechenie.net/kishechnaya-palochka/
Кишечная палочка – что это такое? Первые признаки и симптомы, лечение кишечной палочки у женщин
Кишечная палочка является составляющая естественной микрофлоры кишечника. У нее множество видов, среди которых есть положительные и патогенные. Первые не несут вреда для человека, а вот вторые могут стать причиной ухудшения самочувствия, высока вероятность болезней ЖКТ. Чтобы предотвратить осложнения, нужно знать первые симптомы заражения.
Кишечная палочка — что это такое?
Это палочковидная бактерия, которая принадлежит к семейству энтеробактерий. Грамположительные микроорганизмы живут в тонком и толстом кишечнике, они составляют до 1% микрофлоры кишечника.
Примечание. Существует более 100 видов, большая часть которых непатогенные.
Кишечник заселяется полезными бактериями сразу после рождения младенца. Если количество грамположительных микроорганизмов не превышает норму, то они приносят только пользу – синтезируют витамин К, предотвращают размножение патогенной микрофлоры. При превышении нормальных показателей речь идет о дисбактериозе.
Характеристика и разновидности патогенной микрофлоры
Патогенные разновидности (штаммы) опасны для человека, оказывают токсическое воздействие. Они вызывают отравления и инфекционно-воспалительные болезни.
Все штаммы можно сгруппировать в 5 групп:
- Энтеротоксигенные. Развивается кишечная инфекция, похожая по симптоматике с холерой.
- Энтероинвазивные. Развиваются острые пищевые токсикоинфекции, которые по симптоматике схожи с дизентерией.
- Энтеропатогенные. Наиболее часто встречаются у грудничков, вызывают энтероколит. У взрослых становятся причиной «диареи путешественника».
- Энтерогеморрагические. Штаммы вызывают осложнения, опасные для жизни, например, почечную недостаточность.
- Энтероаггрегативные. Кишечные инфекции встречаются у людей с ослабленным иммунитетом.
Энтероинвазивные и энтерогеморрагические штаммы поражают толстый кишечник, остальные – тонкий.
Как передается кишечная палочка?
Она попадает в окружающую среду с калом. Может существовать в воде, почве, фекалиях и продуктах питания (особенно мясе и молоке), сохраняет жизнеспособность во внешней среде на протяжении длительного времени.
Передается фекально-оральным способом. Источником может стать больной человек или бактерионоситель. Носителем может выступать крупный рогатый скот.
Способы заражения:
- Употребление зараженной пищи или воды. Заразиться можно, если есть мясо, не прошедшее достаточную тепловую обработку, употреблять не вымытые фрукты и овощи, а также пить непастеризованное молоко или сырую воду.
- Контактно-бытовой. Через немытые руки, предметы общего пользования и личной гигиены.
- От матери к ребенку в процессе родов.
- Половым путем (редко).
Бактерии погибают после термической обработки, если температура выше 70 ˚С.
Какие заболевания вызывает инфекция?
Поскольку палочки чаще всего попадают именно в желудочно-кишечных тракт, соответственно они вызывают болезни ЖКТ, а также кишечные инфекции (эшерихиозы), которые сопровождаются симптоматикой интоксикации.
Могут возникнуть такие заболевания:
- энтерит и геморрагический колит;
- воспаление влагалища, матки и придатков;
- простатит, орхит, эпидидимит у мужчин;
- кольпит, вульвовагинит;
- воспаление почек и мочевого пузыря;
- уретрит;
- отит;
- неврит.
Первые признаки и симптомы
Симптомы кишечной палочки зависят от штамма. Эшерихиоз может проявляться в виде пищевого отравления, «диареи путешественника», энтерита или геморрагического колита.
Важно. Первые признаки появляются спустя 2-3 суток после заражения. Инкубационный период некоторых штаммов составляет 3-8 дней.
Симптомы:
- Энтеротоксигенные палочки. Признаки интоксикации слабо выраженные. Первые симптомы – слабость, головокружение, субфебрильная температуры тела, схваткообразная боль в животе. Далее больного беспокоит вздутие, диарея, тошнота и рвота.
- Энтеропатогенные. Симптоматика ярко выраженная, повышается фебрильная температура тела. Появляется рвота, водянистый стул желтого цвета. Энтероинвазивные. Вначале появляются симптомы интоксикации (слабость, озноб, боль в животе). Спустя время стул становится водянистым и частым, может присутствовать слизь.
- Энтерогеморрагические. Инфекция протекает по типу энтероколита. В каловых массах может присутствовать кровь.
Анализ на кишечную палочку: допустимые нормы
В норме в посеве мочи палочковые бактерии составляют до 103, в мазке их быть не должно.
Заражение инфекцией при беременности
Кишечная палочка в моче при беременности – явление распространенное. Если превышена допустимая концентрация, то обязательно выявляется воспалительный процесс.
Штаммы палочек токсичны не только для беременной, но и для плода. Симптомы могут отсутствовать, но мочевыводящие пути инфицируются. Это может привести к преждевременным родам или отхождению околоплодных вод, плацентарной недостаточности. Ребенок рождается недоношенным, с задержкой внутриутробного развития, умственно или физически недоразвитым.
Обнаружение кишечной палочки в различных анализах: значение
Превышается концентрация бактерии чаще при несоблюдении интимной гигиены. Палочки проникают в мочевые пути, влагалище и другие половые органы, провоцируя воспалительные процессы.
Чем выше уровень патогенной микрофлоры, тем тяжелее состояние пациента.
В моче или мочевом пузыре
Кишечная палочка может указывать на инфекцию, патологии мочевых путей и почек. Например, при воспалении почек в 1 мл урины содержится не менее 104, а при воспалении мочевого пузыря – не менее 102.
В гинекологическом мазке
Кишечная палочка в мазке у женщин часто становится причиной воспаления половых органов, значительно возрастает уровень лейкоцитов. Мазок на состав микрофлоры берется из влагалища, уретры и шейки матки.
Кроме воспаления бактерия ослабляет местный иммунитет, провоцирует рост патогенной микрофлоры, становится причиной половых инфекций, которые приводят к бесплодию.
Лечение кишечной палочки выглядит так:
- антибактериальная терапия;
- пробиотики;
- витамины для повышения иммунитета;
- диета.
Длительность и схема лечения зависит от штамма.
Терапия может длиться годами, поэтому нельзя допускать осложнений, при первых симптомах нужно обращаться к врачу.
Диета и народные методы лечения
Для нормализации микрофлоры следует употреблять кисломолочные продукты. Особенно полезны бифидойогурты, ацидофильное молоко и простокваша. Из рациона нужно исключить копчености, жаренные и жирные блюда.
Нормализовать микрофлору можно при помощи топинамбура. 300 г корнеплода нужно проварить в 250 мл молока. После готовности необходимо извлечь топинамбур, а в молоко добавить 2 ст. л. сливочного масла и 1 ст. л. муки. Варить до загустения, затем залить этой массой корнеплод.
Эффективны отвары трав, которые обладают противовоспалительным и антибактериальным действием, например, лапчатка, чистотел, череда, донник, жимолость, подорожник и кукурузные рыльца.
Медикаментозная терапия
Для лечения используется «Амоксиклав», «Офлоксацин», «Фурагин», «Цефотаксим», «Цефтриаксон» и другие антибиотики пенициллиновой группы. Курс 3-10 дней, в зависимости от тяжести течения. Иногда применяют такие медикаменты – «Трихопол», «Гентамицин», «Тержинан».
Для восстановления микрофлоры подойдут вагинальные таблетки – «Гинофлор» или «Вагилак», а также препараты Лактобактерин или Лактацид.
При возникновении симптомов обезвоживания стоит принимать «Ацесоль».
Осложнения и последствия
Могут возникнуть достаточно тяжелые осложнения. При попадании бактерии в брюшную полость, она провоцирует перитонит.
Если же палочка проникает в кровь, инфицируются внутренние органы. Может возникнуть гнойное воспаление желчного пузыря, проток, почек и даже молочных желез. Одни из самых опасных последствий – менингит и сепсис.
Важно. Осложнения чаще возникают на 7-10 день.
Тяжелым последствием является гемолитико-уремический синдром. В случае поражения матки и придатков развивается эндометрит и аднексит.
Чтобы не заразиться, необходимо соблюдать такие рекомендации:
- Мыть руки перед едой и после посещений общественных мест.
- Употреблять мясные, молочные продукты только после термической обработки. Не пить сырую воду.
- Мыть овощи и фрукты теплой водой.
- Предохраняться при половом акте.
- Соблюдать интимную гигиену.
- Носить удобное и свободное нижнее белье.
- Раз в год сдавать анализ мочи и мазок.
Источник: https://attuale.ru/kishechnaya-palochka-chto-eto-takoe-pervye-priznaki-i-simptomy-lechenie-kishechnoj-palochki-u-zhenshhin/
Что такое кишечная палочка и чем она опасна для организма человека? Большая часть этих бактерий является полезной микрофлорой, из некоторых микробных представителей данной группы даже делают лекарства для восстановления биоценоза кишечника. Однако среди E. coli есть и виды, способные вызывать у человека различные инфекционные заболевания – начиная от обычного кишечного расстройства и заканчивая сепсисом.
Как передается кишечная палочка
Поскольку основное место обитания палочки – это кишечник людей и животных, передача данного микроорганизма возможна через все, что загрязнено фекалиями. Потенциально опасными в плане обсеменения кишечной палочкой являются:
- вода, в которую попадают стоки канализации и животноводческих предприятий;
- овощи и фрукты, загрязненные навозом;
- немытые руки;
- не прошедшее термическую обработку мясо и молочные продукты.
Таким образом, к основным причинам инфицирования кишечной палочкой можно отнести:
- низкий уровень личной гигиены;
- несоблюдение основных правил приготовления пищи (недостаточно тщательное мытье продуктов, смешивание сырого и готового, выбор неправильного температурного режима для варки, жарки или запекания и т. д.).
- употребление сырой воды.
Кишечная палочка может и даже должна передаваться от матери новорожденному. Происходит это в первые сутки после рождения малыша. Если у женщины все в порядке с кишечником, ребенок получает от нее «хорошую» кишечную палочку, которая, заселяя толстую кишку крохи, не пускает туда болезнетворных и потенциально-патогенных микроорганизмов, например, таких, как клебсиелла.
Особенности бактерии
Кишечная палочка имеет ряд особенностей, полезных для человека:
- синтезирует витамин К, достаточное содержание которого в организме обеспечивает правильность протекания процесса свертывания крови;
- сдерживает развитие вредных бактерий в кишечнике.
Стоит отметить, что эти полезные свойства реализуются только при условии, что «хорошая» палочка живет в кишечном тракте. Если она попадает в другие органы, в них развивается воспаление. Самый яркий пример – это инфицирование кишечной палочкой мочеполового тракта у женщин, приводящее к циститу и вагиниту (воспалению мочевого пузыря и влагалища соответственно).
Характеристика микроорганизма
Кишечная палочка относится к семейству энтеробактерий, в которое входит также клебсиелла и ряд других микроорганизмов. В отличие от многих своих сородичей, E.
coli не образует спор, хорошо растет на питательных средах, что дает возможность врачам-бактериологам легко выделять ее из фекалий человека и всячески изучать.
Высокие температуры и дезинфицирующие растворы пагубно влияют на рассматриваемый микроорганизм.
Большинство непатогенных эшерихий кишечной палочки синтезируют ферменты, разлагающие лактозу, поэтому их называют лактозопозитивными. Если же это свойство не обнаруживается, кишечные палочки принято считать лактозонегативными.
Гемолизирующая (гемолитическая) кишечная палочка – что это такое? Некоторые E. Coli, помимо ферментов, продуцируют гемолизины (вещества, разрушающие кровь). На питательных средах, содержащих эритроциты, такие бактерии образуют колонии, вокруг которых постепенно появляются зоны гемолиза.
Виды
Кишечные палочки бывают:
- патогенными;
- непатогенными (нормальными).
Патогенная кишечная палочка – это микроорганизм, способный запускать патологический процесс при попадании в кишечник человека.
Виды патогенных кишечных палочек:
- энтерогеморрагические – выделяют токсические соединения, вызывающие кровавую диарею;
- энтеропатогенные – повреждаю микроворсинки кишечника, провоцируя длительное расстройство стула;
- энтероинвазивные – внедряются в поверхностные эпителиальные клетки кишечной стенки, способствуя развитию выраженного воспалительного процесса.
Необходимо отметить, что практически всегда патогенные кишечные палочки по своим свойствам – лактозонегативные либо гемолитические (гемолизирующие).
Заболевания, которые вызывает кишечная палочка
Болезнь, спровоцированную кишечной патогенной палочкой, принято называть эшерихиозом (также можно встретить термин «коли-инфекция»). В большинстве случаев он проявляется острыми кишечными расстройствами. У детей и ослабленных взрослых кишечная палочка может также поражать мочеполовую и нервную системы, вызывая развитие серьезных заболеваний:
- пиелонефрита (воспаление почек);
- менингита (воспалительного процесса в мозговых оболочках).
В самых тяжелых случаях кишечные палочки проникают через поврежденную кишечную стенку в кровоток. Организм на это отвечает генерализованной воспалительной реакцией, которую называют сепсисом.
Симптомы инфекций, вызванных кишечной палочкой
Как проявляется болезнетворная кишечная палочка? Симптомы кишечной палочки определяются в большинстве своем тем, какой разновидностью возбудителя заражен больной.
Так, энтерогеморрагические эшерихии провоцирую повторную диарею и появление в каловых массах крови. Вздутие, бурчание в животе, хронический понос – это результат инфицирования энтеропатогенной кишечной палочкой. Энтероинвазивные E.
Coli вызывают сильные болевые ощущения и профузный водянистый понос.
Помимо этого, на клинику эшерихиоза влияет возраст больного. У ребенка, как правило, кишечная инфекция протекает тяжелее.
У детей
У грудничка болезнетворная кишечная палочка проявляется следующими симптомами:
- коликами – сильной болезненностью в животе, про которую можно узнать по плачу и постоянному беспокойству малыша;
- вздутием живота;
- плохим набором веса;
- учащенной дефекацией;
- изменением запаха фекалий;
- примесью в кале крови;
- ухудшением аппетита.
У более взрослого ребенка «плохая» кишечная палочка вызывает сильный понос, рвоту, повышение температуры тела, схваткообразные боли в животе, общую слабость, тошноту, головную боль. Если с каловыми массами больной теряет много жидкости, развивается еще и обезвоживание.
У мужчин
У мужчин заселение патогенной кишечной палочкой пищеварительного тракта в большинстве случаев становится причиной острого энтерита – по типу отравления.
То есть присутствует рвота, повторная диарея, боль в животе, общая интоксикация и обезвоживание. Также возможна хронизация патологического процесса. При этом указанные симптомы то появляются, то самостоятельно проходят.
Если же инфекция проникает в репродуктивные органы, может возникнуть воспалительный процесс в простате и семенниках.
У женщин
Симптомы обсеменения толстой кишки патогенной кишечной палочкой у женщин схожи с таковыми у мужчин. При попадании возбудителя гематогенным (через кровь) или восходящим (через наружные гениталии) путями во внутренние половые органы возможно воспаление эндометрия и маточных придатков. Это может сказаться на способности женщины к зачатию.
Кроме того, несоблюдение представительницами слабого пола банальных гигиенических правил довольно часто приводит к распространению кишечных палочек из кишечника в вагину и уретру. В этих органах под ее влиянием развивается острое, реже хроническое воспаление.
Кишечная палочка в крови
Проникновение любой бактерии в кровоток называют бактериемией.
Если же на этом фоне возникает генерализованная воспалительная реакция, говорят о сепсисе – тяжелом, часто приводящем к летальному исходу, состоянии.
Поэтому, если в крови человека обнаруживается кишечная палочка, больному грозит серьезная опасность. В такой ситуации спасти жизнь больного может только высококвалифицированная медицинская помощь.
Кишечная палочка в мазке
Получив результаты исследования мазка из влагалища, некоторые женщины узнают о том, что у них есть кишечная палочка. О чем это говорит? Во-первых, о плохой гигиене, во-вторых, о хроническом воспалительном процессе, в-третьих, об угнетении нормальной вагинальной флоры.
Чтобы раз и навсегда избавиться от этой проблемы, необходимо пройти назначенное гинекологом лечение и научиться правильно ухаживать за интимной областью тела: подмываться и вытираться с переда назад, не носить синтетическое белье, отдавать предпочтение трусикам-слипам или шортикам.
Анализы
Если есть подозрение на эшерихиоз, больному стоит сдать кал на бактериологическое обследование. В ходе этого анализа врач может обнаружить лактозонегативные и гемолитические кишечные палочки.
В последующем, чтобы определить их разновидность (серотип), проводятся специальные тесты. Кроме того, у всех «подозрительных» бактерий проверяется чувствительность к антибиотикам.
А это крайне важно для назначения эффективного антибактериального лечения.
Норма
В норме в кале не должны присутствовать патогенные кишечные палочки, даже в минимальном количестве. В перечень «запрещенных» бактерий также относится клебсиелла, синегнойная палочка, сальмонелла, – им в кишечнике здорового человека не место. Основу микрофлоры пищеварительного тракта должны составлять лактобактерии, бифидобактерии и нормальные E. coli.
Диагностика инфекций
Поскольку кишечная палочка – это бактерия, основной метод диагностики коли-инфекции – бактериологический (его еще называют посевом на флору). В зависимости от того, где локализовалась кишечная палочка, больному может быть показано исследование кала (об этом анализе говорилось выше), мочи, вагинальных выделений, сока простаты, крови и т. д.
Лечение
Лечение кишечной палочки с патогенными свойствами предполагает ее полное устранение. Тогда назревает вопрос – чем можно убить кишечную палочку? Здесь на помощь врачам приходят антибиотики и бактериофаги.
Антибиотики
Чтобы узнать, какие препараты будут эффективными от патогенной кишечной палочки, больному проводят тест на чувствительность выделенной бактерии к антибиотикам. Если же времени ждать результат этого анализа нет, врач назначает антибактериальное средство, которое действует на многие микробы, например, что-то из цефалоспоринов или фторхинолонов.
После курса антибиотикотерапии пациентам показано восстановление биоценоза кишечника специальными лекарствами, которые называют пробиотиками.
Бактериофаги
Бактериофаг – это вирус, убивающий бактерии, кишечная палочка его также боится. Поэтому, если в кале пациента обнаружена патогенная E. coli, доктор может выписать один из следующих препаратов:
- Бактериофаг коли жидкий.
- Интести-бактериофаг.
- Колипротейный бактериофаг
Особенности лечения детей
Чем лечить вредную кишечную палочку у ребенка? Если такая бактерия обнаруживается у детей, лечение будет иметь свои особенности:
- Борьбу с эшерихией коли педиатры стараются начинать не с сильных антибактериальных средств, а с бактериофагов и пробиотиков.
- Грудничкам многие антибиотики абсолютно противопоказаны, поэтому врачам порой приходится выкручиваться, чтобы помочь маленькому пациенту.
- Ввиду быстрого развития обезвоживания, при многократной диарее детям обязательно проводят регидратационную терапию.
Кроме того, очень важно, чтобы при заражении болезнетворной кишечной палочкой больной соблюдал назначенную диету, в ином случае никакое лекарство не сможет помочь избавиться от кишечных расстройств.
Профилактика
Профилактика заболеваний, спровоцированных кишечной палочкой, заключается в первую очередь в соблюдении общеизвестных гигиенических правил. Не меньшее значение имеет употребление в пищу тщательно промытых овощей и фруктов, безопасной воды и блюд, приготовленных в соответствии с технологическими нормами.
В заключение необходимо еще раз подчеркнуть, что опасности заражения патогенной эшерихией коли подвержены как взрослые, так и дети. И у тех, и у других инфицирование может спровоцировать очень неприятное патологическое состояние. Но оно излечимо. Главное, не заниматься самодеятельностью и не пить антибактериальные препараты без назначения врача.
Ольга Зубкова, эпидемиологспециально для moizhivot.ru
Источник: https://zhkt.ru/kishechnik/kishechnaya-palochka.html
Как вылечить кишечную палочку медикаментозными средствами за короткий срок?
Кишечной палочкой называют палочковидную бактерию, которая характеризуется наличием огромного количества штаммов. Некоторые из них вызывают у пациентов разнообразные заболевания пищеварительного тракта, а также мочеполовой системы. При появлении кишечной палочки необходимо сразу же начать лечение.
Кишечная палочка может развиваться при снижении иммунитета.
Основной причиной появления кишечной палочки является нарушение микрофлоры кишечника.
Именно поэтому размножается патогенный серотип кишечной палочки.
Причиной ее возникновения достаточно часто являются разнообразные болезни пищеварительного тракта.
Достаточно часто патологический процесс диагностируется на фоне панкреатитов, которыми поражается поджелудочная железа.
Также кишечная палочка может появляться в результате развития заболеваний кишечника – колитов и энтероколитов. На нарушение нормальной микрофлоры кишечника напрямую влияет прием определенных аптечных препаратов, а именно – антибиотиков.
Этими традиционными медикаментами производится подавление микроорганизмов, которыми устраняется возможность появления патогенной микрофлоры. Прием антибактериальных препаратов достаточно часто приводит к возникновению патологии. Человек может заражаться патогенными штаммами фекалльно-оральным путем.
Развивается патология при несоблюдении человеком правил гигиены в период приготовления еды. Если пациент употребляет в пищу немытые овощи и фрукты, то это зачастую приводит к возникновению кишечной палочки. При поливе растений грязной сточной водой после их употребления в пищу может появляться кишечная палочка.
Также причиной ее появления является употребление в пищу сырого молока или плохо прожаренного мяса. Кишечная палочка в большинстве случаев появляется из-за неправильного образа жизни человека. Именно поэтому пациентам рекомендуется внимательно относиться к своему здоровью.
Смотрите видеоролик о кишечной палочке:
Симптоматика патологии
При появлении патологии чувствуется слабость.
Перед тем, как вылечить кишечную палочку, необходимо определить ее симптомы.
При появлении патологии у пациентов наблюдается соответствующая симптоматика, с помощью которой он может самостоятельно определить заболевание.
Несмотря на это, для подтверждения диагноза пациенту необходимо обратиться за помощью к доктору.
Он не только назначает соответствующие анализы, но и устанавливает диагноз по симптоматике. В большинстве случаев появление кишечной палочки у пациентов сопровождается:
- Слабостью;
- Гиперемией;
- Лихорадкой;
- Тошнотой;
- Рвотой.
Читайте: Панкреатин детский: инструкция, описание, аналоги
Также в период развития патологического процесса у пациентов нарушается аппетит. Многие больные жалуются на появление рвоты, которая имеет зеленый цвет.
Также патологическое состояние сопровождается расстройством желудка, которое проявляется сильной диареей. Пациенты утверждают, что при появлении кишечной палочки у них появляется болезненность тянущего характера.
Так как при появлении кишечной палочки кишечник человека очищается самопроизвольно, то это приводит к тому, что через несколько дней симптоматика проходит. При появлении кишечной палочки у взрослых пациентов экстренное медицинское вмешательство не требуется.
Если имеется подозрение на развитие коли инфекции у детей, то им необходимо экстренно предоставить квалифицированную помощь. Это объясняется смертельной опасностью кишечной палочки.
Симптоматика патологического состояния является достаточно развитой. Именно поэтому при появлении первых признаков кишечной палочки пациенту рекомендуется записаться на прием к доктору, который после проведения соответствующей диагностики назначит рациональное лечение пациенту.
Особенности диагностики
Анализ крови для диагностики.
Для проведения эффективного лечения заражения необходимо правильно поставить диагноз.
С этой целью осуществляется назначение соответствующие анализы.
Достаточно эффективным является бакпосев кала, рвоты, мочи.
Испытуемый материал в период проведения анализа высевают в питательную среду.
Если по истечению определенного времени в этой среде вырастают кишечные палочки, то это говорит о положительных результатах. Также для диагностики патологического процесса могут брать анализ кала на дисбактериоз илии проводить копрограмму.
Благодаря данным метолам исследования предоставляется возможность определения определенных микроорганизмов в фекалиях. Анализ на дисбактериоз дает возможность определения кишечных палочек.
Проведение анализов должно осуществляться в лабораторных условиях, что обеспечит их результативность и даст возможность постановки правильного диагноза.
Терапия заболевания
Цефалексин — лечит инфекционные заболевания.
Для терапии кишечной палочки в большинстве случаев осуществляется применение антибиотикотерапии.
Изначально рекомендуется проведение бактериологического посева, что позволяет определить чувствительность к антибиотикам.
Далее проводится выбор определенного традиционного медикамента, к которому кишечная палочка является чувствительной.
Курс лечения пациента с применением аптечных лекарств составляет от 3 до 14 дней.
После того, как пройдет курс лечения, необходимо подождать 2 месяца.
Читайте: Клетчатка: как принимать, какими полезными свойствами обладает
Далее снова проводят бактериологический посев для определения кишечной палочки. Ее отсутствие указывает на успешность терапии.
При обнаружении бактерии пациентам назначается прохождение повторного курса лечения с использованием других антибиотиков. Для лечения инфекционных процессов в мочеполовой системе наиболее часто используются аптечные лекарства в виде:
- Цефалексина;
- Амикацина;
- Цефотаксима;
- Имипенема;
- Левофлоксацина и т.д.
В период антибиотикотерапии взрослым пациентам и детям необходимо выполнять одни и те же правила. Лечение детей, возраст которых составляет менее года, проводится в стационарных условиях. Все остальные пациенты могут проходить терапию дома.
Если у пациента была диагностирована кишечная инфекция, то ему необходимо в обязательном порядке сидеть на щадящей диете. В этот период рекомендуется кушать каши. Которые готовятся на воде, слизистые супы, а также черствый белый хлеб.
Также больному рекомендуются баранки, отварное мясо или рыбу нежирных сортов, отварные овощи, сухарики. Пациенту категорически запрещается употребление копченых, жирных и жареных блюд.
Также доктора не советуют применение пряностей, консервы, соленых и маринованных продуктов. Из меню пациента производится исключение свежих фруктов, молока, жирной рыбы и мяса, наваристых супов.
Антибиотикотерапия и диета характеризуются высокой эффективность лечения только в том случае, если медикаментозные средства и меню для больного подбираются правильно.
Правила лечения
Регидрон регидрационный раствор.
Кроме приема антибиотиков больному необходимо выполнять определенные правила лечения.
Если у пациента наблюдается понос или рвота, то ему необходимо в обязательном порядке пить регидрационные растворы.
С их помощью осуществляется восполнение потерянной жидкости и соли.
При каждом опорожнении кишечника и рвоте необходимо выпивать от 300 до 600 миллилитров регидрационного раствора.
Для его приготовления может использоваться аптечный порошок в виде Трисоля, Регидрона, Глюкосолана.
Также для приготовления раствора можно использовать пищевую соду, соль и сахар. При покупке традиционных медикаментов их необходимо просто развести в воде в соответствии с инструкцией производителя.
Для приготовления домашнего регидрационного раствора необходимо взять литр чистой воды и добавить в него столовую ложку сахара. Также необходимо добавить пищевую соду и соль по 0.5 столовых ложек. При отсутствии в доме регидрационного раствора пациенту рекомендуется питье любых напитков.
Достаточно эффективными являются компоты, морсы, чаи с сахаром. Для обеспечения максимально качественного лечения инфекционных болезней, которые возникают при появлении кишечной палочки, рекомендуется прием энтеросорбентов:
- Полисорба;
- Энтеросгеля;
- Полифепана;
- Смекта;
- Фильтрума и т.д.
Для обеспечения комплексного лечения болезни рекомендуется применение пробиотиков – Баактисубтила, Энтерола, Бифидумбактерина. Если у пациента наблюдается повышение температуры тела более 38 градусов, то ему рекомендуется применение жаропонижающих аптечных лекарств, основой которых является ибупрофен, нимесулид, парацетамол.
С помощью традиционных медикаментов можно устранить не только симптоматику заболевания, но и уничтожить кишечную палочку в организме человека.
Дополнительные рекомендации
Длительность приема антибиотиков до 10 дней.
При тяжелом протекании инфекционного процесса без улучшений пациентам назначают прием нитрофуратов и антибиотиков.
При нетяжелом течении инфекции пациентам в большинстве случаев не делают назначение антибиотиков.
Среди нитрофуратов, которые характеризуются высоким эффектом воздействия, можно выделить Фуразолидон.
С его помощью проводится лечение не только взрослых пациентов, но и детей. Терапия патологического процесса антибилотиками подразумевает применение Амоксициллина, Ципрофлоксацина, Левофлоксацина. Длительность приема антибиотиков и Фуразолидона составляет от 7 до 10 дней.
Для того чтобы уничтожить кишечную палочку можно использовать не только антибиотики, но и бактериофаги в видеинтестибактериофага, пиобактериофага, бактериофага коли жидкого, поливалентного комбинированного жидкого пиобактериофага и т.д.
В период применения данных аптечных лекарств осуществляется устранение патогенной кишечной палочки. При этом не наблюдается уничтожения лакто- и бифидобактерий, которые относятся к нормальной микрофлоре. Именно поэтому их прием начинается с первых дней болезни.
После устранения кишечной палочки пациент должен производить прием пробиотиков – Бифидумбактерина, Бификола и т.д.
С их помощью восстанавливается нормальная микрофлора кишечника в максимально короткое время. Именно поэтому применение данных аптечных лекарств должно осуществляться в течение 14-21 дней.
Если причиной кишечной инфекции является эшерихия коли и она характеризуется генерализированной формой, а также сопровождается холециститом, пиелонефритом, сепсисом, менингитом и т.д., тогда пациенту необходимо осуществлять прием антибиотиков.
Наиболее часто больным назначают цефалоспорины в виде Цефтазидима, Цефуроксима и т.д. Медикаментозная терапия в лечении кишечной палочки будет характеризоваться высокой эффективностью только при правильном подборе препаратов. С этой целью пациенту рекомендуется обратиться за помощью к врачу.
Расскажите друзьям! Расскажите об этой статье своим друзьям в любимой социальной сети с помощью социальных кнопок. Спасибо!
Твит
Телеграм
Класс
Вотсап
Источник: https://PishheVarenie.com/preparaty-dlya-zhkt/kak-vylechit-kishechnuyu-palochku/
Поделиться:
Нет комментариев
Кишечная палочка
Грамотрицательная бактерия, которая в норме встречается в каждом организме. Оптимальной температурой для ее роста и размножения считается 37 градусов, но микроорганизм абсолютно спокойно выдерживает нахождение долгое время и во внешней среде с более низкой температурой. Например, кишечная палочка обнаруживается в водоемах и на предметах обихода, на листьях растений и на почве, она может размножаться даже в продуктах питания – например, в молоке. Но при кипячении жидкостей или прогревании их до температуры 60 градусов в течение 15 минут полностью уничтожается кишечную палочку. Кроме этого, рассматриваемый микроорганизм исчезает при обработке поверхностей дезинфицирующими растворами: хлорамин, формалин и другие.
Виды кишечной палочки
В медицине выделено две крупных группы данного микроорганизма: нормальная и патогенная (болезнетворная). И в каждой из них существуют сотни штаммов! Например, непатогенные палочки могут быть лактозопозитивные, лактозонегативные. Среди болезнетворных палочек различают энтеропатогенные, энтероинвазивные, энтерогеморрагические и другие.
В норме кишечная палочка предназначена для обеспечения активной деятельности желудочно-кишечного тракта, способствует ограничению размножения патогенных микроорганизмов. Нормальное количество рассматриваемого микроорганизма в кишечнике у детей и взрослых абсолютно одинаковое. В случае нарушения содержаний непатогенных бактерий у человека развиваются симптомы дисбактериоза – лечение такого состояния может проходить и в домашних условиях, но в некоторых случаях требуется помощь профессионалов.
Патогенные (болезнетворные) бактерии, попадая в организм человека, провоцируют появление энтеротоксинов и человек жалуется на симптомы отравления – основным признаком является диарея.
Причины
В организме развитие патогенных микроорганизмов чаще связывают с нарушением правил гигиены. Кишечная палочка, например, начинает негативно действовать на состояние здоровья при употреблении в пищу немытых овощей и фруктов, сырого мяса и рыбы (и даже плохо прожаренных/проваренных). Неудивительно, что симптомы кишечной палочки чаще всего констатируются у детей – именно они забывают вымыть руки перед едой и/или после посещения туалета, любят кушать на улице и нередко отказываются мыть яблоки, клубнику и другие фрукты/ягоды.
Следует помнить, что симптомы кишечной палочки могут являться и следствием неправильно проводимой личной гигиеной, эту грамотрицательную бактерию обнаруживают в половой системы женщины после незащищенного полового акта анальным способом или после неправильно проведенных процедур личной гигиены наружных половых органов.
Симптомы кишечной палочки
Признаки распространения патогенных микроорганизмов могут проявляться по-разному и зависят они от того, какая конкретно система организма поражена.
Поражение органов системы пищеварения
Наиболее часто встречающаяся форма поражения кишечной палочкой. Проявляется диареей (понос), которая может достигать уровня 10-12 раз в день. Пациенты жалуются не только на частый стул, но и на ложные позывы. Каловые массы при поражении кишечной палочкой ЖКТ (желудочно-кишечного тракта) имеют жидкий вид, примесь слизи и небольшого количества пены. В крайне редких случаях фиксируется неприятный запах и присутствие «волокон» крови.
У детей в возрасте до 1 года распространение кишечной палочки в ЖКТ проявляется поносом и болями в области живота, повышенным газообразованием – так проходят процессы брожения в организме. В связи с большой потерей жидкости больной чувствует сильную жажду. Для детей и взрослых характерны следующие признаки кишечной палочки, которая распространяется по ЖКТ:
- отсутствие аппетита;
- слабость и сонливость;
- тошнота и рвота (для новорожденных – срыгивание).
Чаще всего проходит трое суток от момента до заражения, а вот длительность заболевания может составлять 10 дней. очень редко инкубационный период длится 24 часа — такое развитие болезни фиксируется при употреблении в пищу большого количества недостаточно проваренного или прожаренного мяса (рыбы).
В некоторых случаях у пациента могут развиться высокая температура тела и локализованные боли в животе — в таком случае следует уложить больного в постель, обеспечить ему обильное питье и немедленно вызвать врача.
Поражение кишечной палочкой мочеполовой системы
Путь попадания кишечной палочки в мочеполовую систему осуществляется «лежит» из прямой кишки – например, при анальном способе половых контактов или неправильно проводимой личной гигиены половых органов. В таком случае клиническая картина может быть различной, но симптомы могут свидетельствовать о цистите, простатите, уретрите, пиелонефрите и других воспалительных процессах в мочеполовой системе. Выявить кишечную палочку и назначить эффективное лечение может только врач!
Диагностика
Диагностические мероприятия по выявлению кишечной палочки сводятся к следующим процедурам:
Бактериологические исследования – специалисты проводят биологический посев на питательную среду. Материал для посева берется индивидуально:
- при половых инфекциях – мазки слизистой влагалища или уретры;
- при проблемах с мочевыводящей системой – моча;
- при инфекциях системы пищеварения – фрагмент рвоты или поноса.
Общие клинические анализы – на исследование берется кровь, моча и кал. Подобное изучение является дополнительным обследованием и не выявляет непосредственно инфекцию, а исключает воспалительные заболевания.
Исследование инструментальными методами – ультразвук, урография и другие.
Одновременно с бактериологическим исследованием специалисты проводят антибиотикограмму (выясняют чувствительность выявленного штамма кишечной палочки к антибиотикам). Без результатов антибиотикограммы эффективное лечение назначить невозможно.
Лечение
Терапевтические мероприятия при диагностированных инфекциях, вызванных кишечной палочкой, начинают с назначения диеты:
- При расстройстве пищеварения рекомендуется диетический стол №4: все блюда готовятся на пару либо подаются в отварном виде. Запрещено употреблять в пищу молочные продукты, перловку, макаронные изделия. Мясные и рыбные блюда, супы следует измельчать или протирать в блендере.
- При заболеваниях мочеполовой системы назначается диетический стол №7, который подразумевает исключение из рациона соли, жирной и острой пищи. Запрещены к употреблению маринованные, соленые овощи и фрукты, шоколад, грибы, горчица.
Медикаментозное лечение:
- антибиотики;
- бактериофаги;
- инфузии специальных препаратов, которые выполняют функцию детоксикации;
- пробиотики.
Лечение детей начинается с применения пробиотиков и бактериофагов, назначения диетического питания. Только при отсутствии положительной динамики назначаются антибактериальные препараты.
Конкретный антибиотик, количество и длительность лечения определяет исключительно специалист!
Дисбактериоз на фоне распространения кишечной палочки – одно из немногих заболеваний, которое можно лечить самостоятельно. Но следует соблюдать осторожность: принимать лечебные меры при диарее и нестабильных симптомах интоксикации можно только на начальной стадии заболевания. Если предпринятые лечебные меры не оказывают должного воздействия в течение 2 суток, то следует немедленно обратиться к врачу.
Профилактика кишечной палочки
В качестве профилактических мер рассматриваются:
- регулярное мытье рук;
- глубокая тепловая обработка продуктов питания;
- исключение употребления в пищу воды и продуктов из неизвестных источников;
- соблюдение правил хранения продуктов питания.
Кишечная палочка — Симптомы и методы лечения, диагностика, полезные препараты для кишечника, советы врачей
Это важно знать каждому, что такой вид бактерий находится в организме у всех людей, но имеет сравнительно маленькое количество — около 1% от массы всех остальных микроорганизмов, населяющих кишечник человека.
При попадании в организм бактерий опасных видов кишечной палочки, человек начинает испытывать симптомы, которые иногда могут быть очень опасны для жизни. Признаки кишечной палочки достаточно своеобразны, чтобы с уверенностью доктор смог поставить точный диагноз.
В настоящее время известно около 150 различных штаммов кишечной палочки. Они могут принести вред организму, вызывая тяжелые заболевания желудочно-кишечного тракта и мочеполовой системы.
Это сопровождается различной симптоматической картиной, очень похожей на симптомы пищевого отравления. Но все-же некоторые из симптомов указывают на бактериологический источник заражения, что является отличительными признаками данного заболевания.
Роль кишечной палочки
Это грамотрицательная бактерия — палочка, которая обитает в нижней части кишечника у всех теплокровных животных. Она также умеет выживать во внешней среде, поэтому именно кишечная палочка свидетельствует о загрязнениях фекалиями при проведении микробиологических исследований.
В своей привычной среде обитания, она прикрепляется к стенкам кишечника с помощью мельчайших ворсинок, расположенных по всей поверхности палочки, где она подолгу может задерживаться на одном месте, образуя колонии.
Заражённой может быть пища, как уже приготовленная, так и свежая, а так же вода. Часто заражение происходит контактным способом, например, при несоблюдении личной гигиены в семье, наличие животных, которые имеют свободный доступ на улицу.
В организме человека, безвредные штаммы кишечной палочки приносят большую пользу своему хозяину, так как выполняют функции, которые не может осилить любой другой микроорганизм:
- синтезируют жизненно необходимый витамин К, принимающий участие во многих химических реакциях в клетках. Он не может попасть в организм извне;
- противостоят росту патогенной микрофлоры в кишечнике.
Многие безвредные человеку штаммы используются в фармацевтической промышленности для получения лекарственных препаратов, улучшающих пищеварение и помогающих при различных нарушениях желудочно-кишечного тракта.
Почему развивается заболевание?
Если человек длительное время принимает антибиотики, то под воздействием агрессивной лекарственной терапии та микрофлора кишечника, которая отвечает за снижение роста патогенных микроорганизмов, чаще всего умирает.
Поэтому наблюдается активный рост патогенной микрофлоры, приводящий к крайне негативным симптомам и нарушению пищеварения.
Помимо антибиотикотерапии, вызвать уменьшение количества нормальной микрофлоры кишечника могут такие заболевания, как панкреатит, энтероколит, колит. Они основаны на нарушении работы поджелудочной железы.
Не все штаммы кишечной палочки способны вызывать заболевания, для того, чтобы это началось, человек должен получить штамм извне. Это может быть употребление загрязнённых фруктов или овощей, воды, недостаточном мытье рук, приготовление еды в условиях, не отвечающим нормальным микробиологическим показаниям.
Таким путём опасный для человека штамм кишечной палочки попадает в желудочно-кишечный тракт и вызывает нарушения пищеварения. Имеется большой шанс отравиться во время походов, когда люди набирают воду из природных источников.
Симптомы отравления кишечной палочкой
Яркость и красочность симптоматической картины напрямую зависят от количества бактерий попавших в организм. Но всегда клинические проявления напоминают картину пищевого отравления, сопровождаемые диспептическими расстройствами, сильной интоксикацией организма.
Основные симптомы при попадании кишечной палочки в желудочно-кишечный тракт:
- нарушения стула. Как правило, это сильная диарея, обильный водянистый стул с изменением его цвета (каловые массы становятся намного светлее, обретая желтоватый цвет и примесь слизи). После возможен длительный запор, у тех лиц, которые склонны к задержке стула после диареи;
- боли в животе и нижней части живота, так как усиливается перистальтика и кишечник в прямом смысле «ходит ходуном», вздутие живота;
- повышенное газообразование;
- обильная рвота и тошнота. Рвотные массы приобретают зелёный цвет, а сама работа не приносит облегчения больному;
- лихорадка, при которой температура может повышаться до критических цифр (39 – 40 градусов);
- проявления интоксикации организма: слабость, вялость, сонливость;
- потеря аппетита.
Если отравление кишечной палочкой было не сильным, то симптоматическая картина протекает гораздо легче.
Часто после обильной диареи и рвоты организм избавляется от возбудителя естественным образом и медицинское вмешательство не требуется, так как симптомы быстро прекращаются.
Какие будут симптомы при попадании бактерии в мочеполовую систему?
В основном, заражение происходит при несоблюдении личной гигиены. При диарее возможно загрязнение нижнего белья, что способствует проникновению кишечной палочки в мочеполовую систему.
Часто, бактерия находится в уретре и мочевом пузыре. С помощью ворсинок она прикрепляется к стенке и начинает продуцировать токсины. Слизистая оболочка отекает, что может привести к нарушению оттока мочи и боли при мочеиспускании.
Возможно появление крови или слизистых прожилок с кровью в выделениях, так как при мочеиспускании колонии бактерий отрываются и травмируют слизистую оболочку.
Заражение других органов и систем организма
Проникновение кишечной палочки в другие органы – явление редкое, но иногда случается. Например, заражение плода в утробном периоде, когда бактерия проникает через гематоэнцефалитический барьер и заражает ребёнка.
Возможно также попадание бактерии в кровь через повреждённую слизистую оболочку, что вызывает сепсис и таким образом проникает во все органы и ткани организма.
Для лечения таких осложнённых бактериальных инфекций обязательно необходимо проводить в стационаре, так как заболевание может угрожать жизни и вызвать смертельный исход.
Заражение кишечной палочкой у детей
В детском возрасте такое заболевание проходит намного тяжелее, чем у взрослых, в связи с не окрепшим организмом, малым количеством антител и ещё не сформировавшимся до конца иммунитетом.
Таким образом, у ребёнка сразу начинаются признаки отравления, сопровождаемые зеленой рвотой, диарея, высокая, стойкая температура и сильнейшая интоксикация.
Часто, кишечная палочка провоцирует у детей такие симптомы, как желтуха, психопатические расстройства и нарушения сна. У взрослых, как правило, таких симптомов не наблюдается. При адекватном лечении сон и беспокойство ребёнка приходят в норму, а все другие симптомы постепенно уменьшаются.
Обязательно нужно обратиться к врачу, потому что сразу необходимо начинать лечение, чтобы не нанести непоправимый вред жизнедеятельности многих систем организма.
Лечение
В тяжелых случаях, пациента всегда госпитализируют и первое, что нужно сделать, это сдать кал или рвотные массы на посев, чтобы определить каким именно штаммом кишечной палочки был заражён пациент.
Определение возбудителя позволяет более точно подобрать антибиотикотерапию, так как это основной принцип лечения отравлений кишечной палочкой.
Кроме того, рекомендуют пить большое количество чистой воды, чтобы возместить потери жидкости организмом во время рвоты и поноса. При сильной интоксикации и потере жидкости назначают внутривенное вливание растворов с электролитами.
Также обязательно необходимо принимать препараты, снижающие кислотность желудка, например, Омепразол. А для увеличения полезной микрофлоры кишечника назначают такие лекарства, как Линекс, Бактериофаг, а для сгущения каловых масс применяют Диосмектит.
Специальная диета
Помимо этого назначается специальная диета, при которой разрешено употреблять определённые виды продуктов и необходимое количество жидкости.
При поражении желудочно-кишечного тракта назначается диета №4. В ней разрешается пить много воды, до 3-4 литров в сутки, пища должна содержать достаточное количество белков, но сильно урезается количество углеводов и жиров. Вся пища должна быть протертой, чтобы исключить травмирование кишечника и увеличить всасываемость полезных веществ в кровь.
Такая диета необходима для восстановления слизистой оболочки кишечника, уменьшения раздражения и отечности, а так же, с целью снизить процессы брожения и газообразования.
При поражении мочевой системы назначается стол под номером 7. Работа такой диеты направлена на восстановление нормального уровня жидкости и водно – солевого обмена.
Диета специфична, потому как из рациона полностью исключается соль и ограничивается количество воды за сутки – до 1 литра. Также обязательно уменьшается количество белка, который под действием веществ, выделяемой кишечной палочкой превращается в токсин и только ухудшает состояние пациента.
Подробное описание продуктов и примерное меню пациенту обязательно выдают в лечебном учреждении и инструктируют при выписке домой, чтобы больной мог самостоятельно продолжать питаться необходимыми продуктами.
Профилактика заражения кишечной палочкой
Отравление свидетельствует о том, что кишечной палочкой были заражены какие-либо продукты или вода. Поэтому обязательно нужно изучить последнюю пищу, которую кушал человек и утилизировать остатки, чтобы никто из членов семьи больше не пострадал.
Важно мыть фрукты и овощи, так как в почве могут обитать штаммы бактерий и недостаточное мытьё может привести к заражению. Также, запрещается пить воду с неизвестных источников, следить за маленькими детьми, когда они находятся на улице.
Обеззараживание и стерилизация медицинского инструментария должны производится согласно нормам эпидемиологических исследований и предписаний. Заражение внутри стационара недопустимо.
Также, обязательно тщательно мыть руки, чтобы исключить заражение фекально-оральным способом. Всё, с чем контактировал заражённый кишечной палочкой человек обязательно необходимо обработать бытовой химией и тщательно вымыть, чтобы не допустить заражение остальных членов семьи.
Итог
Заражение кишечной палочкой всегда сопровождается определенными симптомами и доставляют сильные неудобства для пациента. Важно быть осторожным и соблюдать меры профилактики.
Таким образом, человек сможет обезопасить себя и близких от заражения. А если это все-же произошло, то обязательно нужно обратиться в специальное медицинское учреждение для того, чтобы получить консультацию специалиста.
Это позволит подобрать правильное лечение, выбрать соответствующую диету и получить направление для сдачи необходимых анализов.
Кишечная палочка
Кишечная палочка 0157: Н7 обычно вызывает острую кровянистую диарею, и, иногда, гемолитико-уремический синдром. Симптомы включают схваткообразную абдоминальную боль и диарею, которая может сопровождаться обильной примесью крови. Лихорадка при данной инфекции незначительна. Диагностика основана на культуральном исследовании кала и на исследовании токсинов. Лечение, поддерживающее обоснованность назначения антибиотиков, обсуждается.
Как проходит заражение
Несмотря на то что более 100 серотипов кишечной палочки продуцируют токсин Шига, а также подобные ему токсины, кишечная палочка 0157: Н7 является наиболее распространенной в Северной Америке. В некоторых частях США и Канады инфекция, обусловленная кишечной палочкой 0157: Н7, может быть более частой причиной кровавой диареи, нежели шигеллез и сальмонеллез. Данная инфекция может возникнуть у людей любого возраста, однако острые случаи наиболее часто возникают у детей и пожилых лиц. Резервуаром для кишечной палочки 0157: Н7 являются жвачные животные, поэтому вспышки и спорадические случаи данной инфекции возникают при употреблении в пищу недостаточно приготовленной говядины (особенно говяжьего фарша) или непастеризованного молока. Пища или вода, контаминированные коровьим навозом или сырым говяжьим фаршем, также могут стать источником распространения инфекции. МО может также передаваться фекально-оральным путем (особенно среди младенцев, носящих подгузники).
После попадания в желудочно-кишечный тракт человека кишечная палочка 0157: Н7 и схожие штаммы кишечной палочки (называемые энтерогеморрагическими кишечными палочками), продуцируют большие количества различных токсинов в просвете толстой кишки. Эти токсины схожи с мощными цитотоксинами, которые продуцируют Shigella dysenteriae 1 -го типа, холерный вибрион и другие энтеропатогены. Обнаружено, что эти токсины способны напрямую повреждать клетки слизистой оболочки и клетки эндотелия сосудов стенки кишки. При всасывании они оказывают токсическое воздействие на эндотелиальные клетки других сосудов, например почечных.
Симптомы и признаки кишечной палочки
Инфекция, обусловленная кишечной палочкой 0157: Н7, обычно начинается остро со схваткообразных абдоминальных болей и водянистой диареи, которая может сопровождаться обильной примесью крови в течение 24 часов. Некоторые пациенты описывают диарею как кровь без кала, что легло в основу термина «геморрагический колит». Лихорадка обычно отсутствует или является незначительной. Иногда спонтанно температура тела может подниматься до 39 °С. При неосложненной инфекции диарея может продолжаться 1—8 дней.
Приблизительно в 5 % случаев (в основном у детей младше 5 лет и взрослых старше 60 лет) возникает такое осложнение как гемолитикоуремический синдром, который в типичных случаях возникает на 2 неделе заболевания. Как с этим осложнением, так и без него может быть летальный исход, особенно у пожилых лиц.
Диагностика кишечной палочки
Инфекцию, обусловленную кишечной палочкой 0157: Н7, необходимо дифференцировать с другими инфекционными диареями. Для этого необходимо изолировать эти МО из культур кала. Часто клиницист должен запросить лабораторию о поиске именно этого МО. Ввиду того что кровавая диарея и острая абдоминальная боль без лихорадки могут иметь различную неинфекционную этиологию, вероятность инфекции, обусловленной кишечной палочкой 0157: Н7, должна быть рассмотрена при подозрении наишемический колит, кишечную инвагинацию и синдром воспаленной кишки. Быстрое исследование кала на токсин Шига может оказать помощь в диагностике этого заболевания. Пациенты, находящиеся в группе риска по неинфекционным диареям, могут нуждаться в проведении ирригоскопии. При проведении последней можно выявить эритему и отечность сигмовидной кишки; бариевая клизма обычно доказывает наличие отека, при этом выявляется симптом отпечатка большого пальца.
Лечение и профилактика кишечной палочки
В основном лечение при данной инфекции — поддерживающее. Несмотря на то что кишечная палочка чувствительна к наиболее часто используемым антимикробным препаратам, антибиотики не влияют на эволюцию симптомов, устранение носительства или профилактику гемолитико-уремического синдрома. К тому же есть подозрение, что фторхинолоны способствуют выделению энтеротоксина.
Через неделю после перенесенной инфекции пациенты высокого риска по развитию гемолитико-уремического синдрома (например, дети до 5 лет и пожилые люди) должны быть осмотрены для выявления ранних признаков, таких как протеинурия, гематурия, наличие останков эритроцитов и повышенный уровень сывороточного креатинина. Отечность и гипертензия развиваются позже. Пациенты с осложнениями скорее всего будут нуждаться в интенсивной терапии, включая диализ и другие специфические способы терапевтического воздействия, в медицинских центрах 3-го порядка.
Правильное обезвреживание кала инфицированных людей, хорошая гигиена и тщательное мытье рук с мылом ограничивают распространение инфекции. Меры профилактики, которые могут оказаться эффективными в условиях детского сада, включают разделение инфицированных и неинфицированных детей по разным группам или разрешение инфицированным детям посещать данные учреждения после 2 отрицательных культуральных исследований кала. Пастеризация молока и тщательное приготовление говядины являются эффективными в профилактике пищевой передачи инфекции. Важно сообщать о случаях кровавой диареи органам здравоохранения, так как своевременное вмешательство последних может предотвратить возникновение новых случаев инфекции.
Не знаете как подобрать клинику или врача по приемлемым ценам? Единый центр записи по телефону +7 (499) 519-32-84.